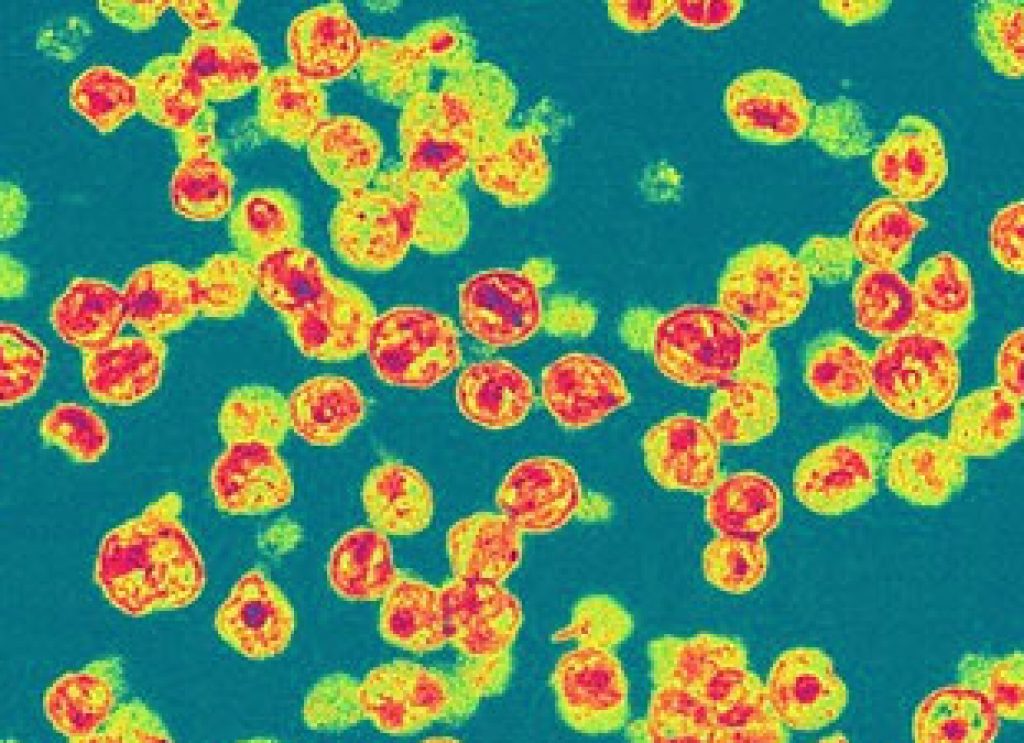

AsianScientist (Jan. 21, 2013) – Researchers in Australia have developed a way to use HIV to beat HIV in the laboratory.
Associate Professor David Harrich, from the Queensland Institute of Medical Research’s Molecular Virology Laboratory, has determined how to modify a protein in the virus, so that it instead provides strong, lasting protection from infection.
“This is like fighting fire with fire,” said Harrich, who runs the only research laboratory and containment facilities in Queensland working with the HIV virus.
In a study published in the journal Human Gene Therapy, the researchers engineered the “Nullbasic” protein, a mutant of the HIV-1 Tat protein, which has shown the ability to stop the virus from replicating in a lab environment. Animal trials are due to start this year.
“I have never seen anything like it. The modified protein works every time,” Harrich said.
“You would still be infected with HIV, it’s not a cure for the virus. But the virus would stay latent, it wouldn’t wake up, so it wouldn’t develop into AIDS. With a treatment like this, you would maintain a healthy immune system,” he said.
The article can be found at: Apolloni A et al. (2013) A mutant Tat protein provides strong protection from HIV-1 infection in human CD4+ T cells.
——
Source: QIMR; Photo: wellcome images/Flickr/CC.
Disclaimer: This article does not necessarily reflect the views of AsianScientist or its staff.












